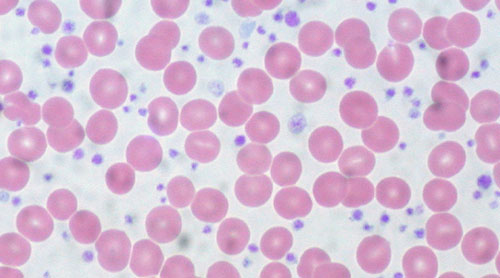
povecan broj trombocita

Ovo istraživanje možda je otkrilo prvi novi indikator za karcinom u zadnjih 30 godina. Trombociti su najmanji proteini koji čine krv, a odgovorni su za stvaranje ugrušaka i spriječavanje daljnjeg krvarenja na mjestu neke povrede.
Ovo istraživanje možda je otkrilo prvi novi indikator za karcinom u zadnjih 30 godina. Trombociti su najmanji proteini koji čine krv, a odgovorni su za stvaranje ugrušaka i spriječavanje daljnjeg krvarenja na mjestu neke povrede.
Zbog njihove iznimno važne funkcije u tijelu, potrebno je imati dovoljno trombocita, ali, ako ih je previše, dolazi do stanja koji se zove trombocitoza. Najnovije istraživanje sugerira da ovaj poremećaj krvi može biti i opasniji nego se sada smatra i da, kod nekih osoba, može biti vrlo rani znak karcinoma, piše International Business Time.
Studija, objavljena online u The British Journal of General Practice, otkriva da visok broj trombocita kod nekih slučajeva može biti jedini vanjski pokazatelj karcinoma. Prema studiji, oko jedna trećina pacijenata sa trombocitozom koji imaju karcinom pluća ili debelog crijeva nemaju nikakvih drugih simptoma karcinoma. Ovo je istraživanje možda otkrilo prvi novi indikator za karcinom u zadnjih 30 godina.
Karcinom bi se mogao dijagnosticirati ranije
Studija je proučavala medicinske kartone 40 tisuća pacijenata, a rezultati pokazuju da je kod više od 11 posto muškaraca i 6 posto žena iznad četrdesete godine koji su imali velik broj trombocita, otkriven karcinom unutar godine dana. Broj i raste ako je osoba imala i drugi put unutar šest mjeseci velik broj trombocita.
“Znamo da je ključ izlječenja što ranija dijagnoza. Naše istraživanje pokazuje da se kod određenog broja ljudi karcinom može dijagnosticirati tri mjeseca ranije ako se uoči trombocitoza, a ovo vrijeme čini veliku razliku”, kaže doktorica Sarah Bailey, autorica studije.
Prema ovome timu znanstvenika, konzervativna je procjena da ako 5 posto ljudi sa karcinomom ima trombocitozu prije nego im je dijagnosticiran karcinom, tada trećina ove grupe može potencijano mjesecima ranije imati dijagnozu karcinoma što je krucijalno za bolji oporavak i preživljavanje.
Nova studija dokazuje vezu trombocitoze i karcinoma
“Naše saznanje o trombocitozi pokazuje čvrstu vezu sa karcinomom, osobito kod muškaraca. Važno je moći isključiti karcinom istraživanjem trombocitoze”, kaže dr Baily. Prema John Hopkins Medicine, normalni broj trombocita je između 150 do 450 tisuća za mikrolitru krvi. Trombocitoza znači imati više trombocita od gornje granice, a trombocitopenija manje od donje granice.
Postoje dvije vrste trombocitoze, primarna i sekundarna. Primarna nastaje zbog nepoznatih razloga, dok je sekundarnoj uzrok tekuće medicinsko stanje kao anemija ili infekcija. Uobičajeni simptomi previše trombocita su modrice na koži ili krvarenje iz nosa, usta, desni ili želuca i intestinalnog trakta. Kod nekih slučajeva stanje može izazvati bol, oticanje, utrnulost i trnce u rukama i stopalima. piše





























